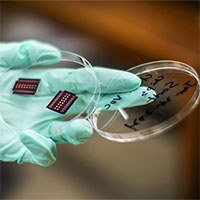

Đời sống
Đời sống
Các thông tin mới nhất về y học sức khỏe như y học sức khỏe ăn uống, sức khỏe điều trị, sức khỏe thực phẩm, sức khỏe dinh dưỡng, sức khỏe uống rượu, sức khỏe thuốc, sức khỏe và đời sống, sức khỏe sinh sản

Yoga thật sự có tác dụng giảm đau lưng?
Nếu bạn bị đau lưng thì bạn không hề đơn độc vì rất nhiều người cũng đang khổ sở với vấn đề này. May mắn là bạn không hề bất lực trước cơn đau lưng.
Đăng ngày: 09/06/2021

Những điều cần biết về hiến máu nhân đạo
Hiến máu nhân đạo, một hành động thể hiện sự chia sẻ của những người khỏe mạnh và giúp đỡ những người bệnh đang cần máu để điều trị cũng như duy trì sự sống.
Đăng ngày: 09/06/2021

Socotra - "Đảo long huyết" độc nhất của Yemen bị đe dọa
Các nhà nghiên cứu cảnh báo về tác động tiêu cực của biến đổi khí hậu lên hệ sinh thái độc nhất vô nhị tại hòn đảo Socotra của Yemen.
Đăng ngày: 09/06/2021

Người phụ nữ tự nhận sinh 10 gây xôn xao
Một phụ nữ ở tỉnh Gauteng, Nam Phi tuyên bố hạ sinh 10 em bé, phá vỡ kỷ lục thế giới do cô Halima Cissé, người Mali, nắm giữ hồi tháng trước.
Đăng ngày: 09/06/2021

Cách tự kiểm tra nguy cơ tử vong khi mắc Covid-19 với hai chỉ số
Nghiên cứu từ nhóm chuyên gia tại Đại học Y khoa Washington, Mỹ, phát hiện nồng độ oxy trong máu và nhịp thở có thể cảnh báo nguy cơ tử vong ở một người khi họ mắc Covid-19.
Đăng ngày: 08/06/2021

Dấu hiệu nhận biết bạn cần thay lốp xe
Lốp xe ảnh hưởng rất lớn đến sự êm ái của một chiếc xe, nếu bánh xe mòn quá nhiều, quá cũ sẽ gây mất an toàn khi tham gia giao thông.
Đăng ngày: 08/06/2021

Vẻ đẹp kỳ ảo của thung lũng đá trắng như ở hành tinh khác
Thung lũng đá trắng - kiệt tác thiên nhiên nổi tiếng ở Kamchatka, Nga được cho là những chiếc thuyền mà các vị thần phơi khô nhưng lại bỏ quên.
Đăng ngày: 07/06/2021

Cách phòng ngừa đột tử do tập luyện, hoạt động gắng sức
Đột tử rất dễ xảy ra khi khi tập luyện, hoạt động gắng sức ở người trẻ, người có các bệnh nền mãn tính, nhất là bệnh lý về tim mạch.
Đăng ngày: 07/06/2021

Lần đầu tiên đo được khối lượng nhiễm sắc thể của con người
Lần đầu tiên, các nhà khoa học có thể đo chính xác khối lượng của nhiễm sắc thể người.
Đăng ngày: 07/06/2021

Kinh nghiệm ăn vải không bị ngộ độc, không bị nóng
Quả vải là loại trái cây phổ biến trong mùa hè. Tuy nhiên, loại quả này lại có tính nóng, dễ gây nguy hiểm cho cơ thể nếu ăn quá nhiều.
Đăng ngày: 07/06/2021

Nghiên cứu mới về mức hủy diệt của thảm họa sóng thần Storegga
Một nghiên cứu mới cho rằng nhiều thành phố ở bờ biển Scotland sẽ bị tàn phá, nếu trận sóng thần Storegga xảy ra ở thời hiện đại.
Đăng ngày: 07/06/2021
"Mũi điện tử" phát hiện tế bào ung thư trong mẫu máu
Công cụ này có thể nhận biết sự khác nhau của hợp chất hữu cơ dễ bay hơi phát ra từ tế bào ung thư và tế bào bình thường trong huyết tương.
Đăng ngày: 07/06/2021

2 loại virus cúm gây tử vong ở người gần như đã tuyệt chủng
Theo các báo cáo thu thập được, có rất ít trường hợp bị cúm xảy ra trong đại dịch COVID-19. Điều này khiến cho các nhà khoa học đặt ra câu hỏi “liệu một số virus cúm đã tuyệt chủng chăng?”
Đăng ngày: 07/06/2021

Ấn Độ phát hiện 12.200 biến thể virus corona, biến thể Delta lây nhanh "chóng mặt"
Nghiên cứu của Hiệp hội gene SARS-CoV-2 Ấn Độ (Insacog) cho thấy biến thể Delta của virus corona chủng mới đã lấn át hơn 12.200 biến thể khác và khiến Ấn Độ vỡ trận trong đợt dịch thứ hai.
Đăng ngày: 07/06/2021

Các biến thể của virus gây đại dịch cúm ngày càng nguy hiểm
Quá trình tiến hóa của virus gây đại dịch cúm năm 1918 có những điểm tương đồng đại dịch Covid-19, như nhiều đợt dịch liên tiếp với nhiều biến chủng khác nhau và các đợt bùng phát sau mức độ nguy hiểm hơn đợt trước.
Đăng ngày: 06/06/2021

NASA đưa ra sứ mệnh ngăn chặn biến đổi khí hậu
NASA sẽ đưa ra những sứ mệnh mới, tập trung vào việc ngăn sự biến đổi khí hậu của Trái đất.
Đăng ngày: 05/06/2021
Tiêu điểm



